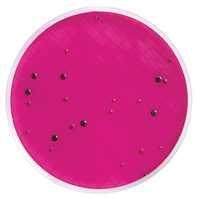
BF839菌计数选择培养基图片

相关产品推荐更多 >
万千商家帮你免费找货
0 人在求购买到急需产品
- 详细信息
- 技术资料
- 库存:
45
- 英文名:
Tryptone
- 保质期:
有效期3年
- 供应商:
上海一研
- 保存条件:
室温避光
- 规格:
500g
【操作步骤】
(一)准确称量试剂:根据不同的菌类和用途,选择适宜的培养基,培养基所需试剂必须纯净。
(二)校正pH值:产品仅限于科研将称量好的培养基各种成分放入容器内,标记划线,加热溶解,补充水分,测定酸碱度,常用pH6.8~8.0的精密试纸或酸度计测定。用1N NaOH和1N HCl调节pH值到适宜范围内。
(三)过滤:将玻璃漏斗置铁架上,再用纱布夹棉花或用滤纸放在漏斗中,将上述培养基倒入其中过滤至透明。
(四)分装:将过滤后的培养基分装于中试管或三角瓶内(试管内每支装5mL;三角瓶中装100~150ml),塞好棉塞用牛皮纸包扎好,准备灭菌。
(五)灭菌:培养基的灭菌,常用高压蒸汽灭菌法。一般微生物的营养细胞在水中煮沸后即被杀死,但细菌的芽胞有较强的抗热性,须经高压蒸汽灭菌才能达到彻底灭菌的目的。根据蒸汽温度随压力升高而上升的原理,即压力越大,蒸汽温度就越高。因此,在同一温度条件下,采用高压蒸汽灭菌比干热灭菌法效果要好。而且在湿热情况下,菌体吸收水分后,其蛋白质易于凝固变性,因为蒸汽的穿透力强,杀菌效果好。
公司提供的培养基品种全面,价格优惠、实验方法、培养基使用说明,均可我们,或咨询在线客服,我们将竭诚为您服务,详情请咨询我们客服专员!
中文名称:胰蛋白胨
英文名称:Tryptone
产品规格:500g
本品是优质酪蛋白用胰酶水解生成的高纯度蛋白胨产物,并经超滤处理,确保了产品的纯度、均一性和溶解性。本产品常与酵母膏(例如本公司的YT439酵母膏)一起用于细菌等培养基如LB、LB-Agar等的配制,品质及使用效果达到进口同类产品标准,色泽基本一致,用于DH5α和TG1细菌培养测试时,细菌的生长曲线完全一致。本产品为接近白色或微黄色粉末,水解度高、溶解性好,胨分子量更丰富均衡,且色泽浅、高压灭菌后无沉淀、pH值中性。
本产品富含游离氨基酸与不同分子量肽类。本产品作为微生物培养有机营养源用途广泛,不仅适用于实验室的微生物培养,并且在抗生素、维生素、氨基酸、有机酸、酶制剂、医药工业、生化制品等很多工业领域都有广泛应用。
储存条件:室温避光,有效期3年。
【实验方法】
1.培养基阳性组:取稀释后的各试验菌悬液1ml分别加于预先制备的试管培养基中,每种细菌接种两支试管。同时分别取1ml菌悬液加于无菌空平皿中,用于计数,每种细菌做两个平板。
2. 产品仅限于科研培养基阴性组:即空白对照,即不添加菌液。
3. 接种量计数:平皿中,细菌倾注培养基,霉菌和白色念珠菌倾注培养基。同时每种培养基做1个空白。
4. 培养条件:
无菌检查:20~25℃培养14天或直至出现浑浊(不超过14天)
MPN计数:30~35℃培养箱中培养3天
控制菌检查:30~35℃培养箱中培养18~24小时
倾注计数用的的培养基平板置30~35℃培养箱中培养3天
倾注计数用的培养基平板置20~25℃培养箱中培养3~5天
特点:
(1)胰蛋白胨S培养基 它是1962年由Murashige和Skoog为培养烟草细胞而设计的。特点是无机盐和离子浓度较高,为较稳定的平衡溶液。其养分的数量和比例较合适,可满足植物的营养和生理需要。它的硝酸盐含量较其他培养基为高,广泛地用于植物的器官、花药、细胞和原生质体培养,效果良好。有些培养基是由它演变而来的。
(2)B5培养基 是1968年由Gamborg等为培养大豆根细胞而设计的。其主要特点是含有较低的铵,这可能对不少培养物的生长有抑制作用。从实践得知有些植物在B5培养基上生长更适宜,如双子叶植物特别是木本植物。
(3)White培养基 是1943年由White为培养番茄根尖而设计的。1963年又作了改良,称作White改良培养基,提高了MgSO4的浓度和增加了鹏素。其特点是无机盐数量较低,适于生根培养。
(4)N6培养基 是1974年朱至清等为水稻等禾谷类作物花药培养而设计的。其特点是成分较简单,KNO3和(NH4)2SO4含量高。在国内已广泛应用于小麦、水稻及其他植物的花药培养和其他组织培养。
(5)KM-80培养基 它是1974年为原生质体培养而设计的。其特点是有机成分较复杂,它包括了所有的单糖和维生素,广泛用于原生质融合的培养。
含量测定≥98%cytochrome c-1,CYC1 ELISA kit
英文名称:GLP-1 (7-36)锌指蛋白211抗体
英文名称:GLUT3锌指蛋白749抗体
英文名称:Gelsolin酸化zeta相关蛋白70抗体
英文名称:GHRHZ DNA结合蛋白抗体
英文名称:GFAP锌结合醇脱酶结构域蛋白1抗体
英文名称:GFP锌指蛋白481抗体
英文名称:GHR锌指蛋白ZBTB34抗体4-羟基酸(标准品)GoatF(ab)Anti-MouseIgGH&L(TexasRed®)
4-羟基苄醇;对羟基醇(标准品)RabbitAnti-MouseIgGH&L(FITC)
4-羟基间二酸(标准品)RabbitAnti-MouseIgGH&L(TRITC)
4-异基酸(标准品)RabbitAnti-MouseIgGH&L(TexasRed®)
4-[2-(5-氯-2-基酰)-基]-磺...RabbitAnti-MouseIgGH&L(Biotin)
4-差向四环素(标准品)RabbitAnti-MouseIgGH&L(HRP)
5'-脱-5-氟胞苷(5’-DFCR)(标准品)RabbitAnti-MouseIgGH&L(AlkalinePhosphatase)
5-水杨酸,美沙拉秦(标准品)RabbitAnti-RatIgGH&L(FITC)
5-基-2,4-二烯酸(标准品)RabbitAnti-RatIgGH&L(TRITC)
5-氮胞苷/阿扎胞苷(标准品)RabbitAnti-RatIgGH&L(TexasRed®)
5-基蜂蜜曲霉素(标准品)RabbitAnti-RatIgGH&L(Biotin)
5-羟基色氨酸(标准品)RabbitAnti-RatIgGH&L(HRP)
5-三氟基尿嘧啶(标准品)RabbitAnti-RatIgGH&L(AlkalinePhosphatase)
5-硝基糠二酸酯(标准品)RabbitAnti-GoatIgGH&L(FITC)
6-基-2-萘酮(标准品)RabbitAnti-GoatIgGH&L(TRITC)
胰蛋白胨朝藿定C进口/国产phospho-SYT6(Thr418) 酸化突触蛋白6抗体含量:Epmedin C
洛伐他汀进口/国产MtTF1 线粒体转录因子1抗体含量:Lovastatin
芒柄花黄进口/国产BarX1 BarX1蛋白抗体含量:Formononetin
拟人参皂苷F11进口/国产GOLPH2/GP73 高尔体膜蛋白GP73抗体含量:Pseudoginsenoside F11
人参皂苷Rb1进口/国产phospho-CstF64(Ser83) 酸化细胞分裂相关蛋白CSTF64抗体含量:Ginsenoside Rb1
人参皂苷Rb2进口/国产TET1/CXXC6 Ten-eleven转运因1蛋白抗体含量:Ginsenoside Rb2
人参皂苷Rb3进口/国产Calcium Sensing Receptor/CaSR 钙敏感受体1抗体含量:Ginsenoside Rb398%20mgPeroxiredoxin 4,PRDX4 ELISA Kit
英文名称:phospho-Eg5(Thr926)分选连接蛋白11抗体
英文名称:EID1分选连接蛋白6抗体
英文名称:EB3子生成相关蛋白3抗体
英文名称:EIF5酸化非受体酪氨酸激酶c-Abl抗体
英文名称:ELAC2SRC有丝分裂相关蛋白68抗体
英文名称:phospho-MEK1 (Ser385)SH3BGRL2蛋白抗体
英文名称:phospho-MEK1 (Thr292)钠离子通道相关蛋白1抗体
(一)准确称量试剂:根据不同的菌类和用途,选择适宜的培养基,培养基所需试剂必须纯净。
(二)校正pH值:产品仅限于科研将称量好的培养基各种成分放入容器内,标记划线,加热溶解,补充水分,测定酸碱度,常用pH6.8~8.0的精密试纸或酸度计测定。用1N NaOH和1N HCl调节pH值到适宜范围内。
(三)过滤:将玻璃漏斗置铁架上,再用纱布夹棉花或用滤纸放在漏斗中,将上述培养基倒入其中过滤至透明。
(四)分装:将过滤后的培养基分装于中试管或三角瓶内(试管内每支装5mL;三角瓶中装100~150ml),塞好棉塞用牛皮纸包扎好,准备灭菌。
(五)灭菌:培养基的灭菌,常用高压蒸汽灭菌法。一般微生物的营养细胞在水中煮沸后即被杀死,但细菌的芽胞有较强的抗热性,须经高压蒸汽灭菌才能达到彻底灭菌的目的。根据蒸汽温度随压力升高而上升的原理,即压力越大,蒸汽温度就越高。因此,在同一温度条件下,采用高压蒸汽灭菌比干热灭菌法效果要好。而且在湿热情况下,菌体吸收水分后,其蛋白质易于凝固变性,因为蒸汽的穿透力强,杀菌效果好。
公司提供的培养基品种全面,价格优惠、实验方法、培养基使用说明,均可我们,或咨询在线客服,我们将竭诚为您服务,详情请咨询我们客服专员!
中文名称:胰蛋白胨
英文名称:Tryptone
产品规格:500g
本品是优质酪蛋白用胰酶水解生成的高纯度蛋白胨产物,并经超滤处理,确保了产品的纯度、均一性和溶解性。本产品常与酵母膏(例如本公司的YT439酵母膏)一起用于细菌等培养基如LB、LB-Agar等的配制,品质及使用效果达到进口同类产品标准,色泽基本一致,用于DH5α和TG1细菌培养测试时,细菌的生长曲线完全一致。本产品为接近白色或微黄色粉末,水解度高、溶解性好,胨分子量更丰富均衡,且色泽浅、高压灭菌后无沉淀、pH值中性。
本产品富含游离氨基酸与不同分子量肽类。本产品作为微生物培养有机营养源用途广泛,不仅适用于实验室的微生物培养,并且在抗生素、维生素、氨基酸、有机酸、酶制剂、医药工业、生化制品等很多工业领域都有广泛应用。
储存条件:室温避光,有效期3年。
【实验方法】1.培养基阳性组:取稀释后的各试验菌悬液1ml分别加于预先制备的试管培养基中,每种细菌接种两支试管。同时分别取1ml菌悬液加于无菌空平皿中,用于计数,每种细菌做两个平板。
2. 产品仅限于科研培养基阴性组:即空白对照,即不添加菌液。
3. 接种量计数:平皿中,细菌倾注培养基,霉菌和白色念珠菌倾注培养基。同时每种培养基做1个空白。
4. 培养条件:
无菌检查:20~25℃培养14天或直至出现浑浊(不超过14天)
MPN计数:30~35℃培养箱中培养3天
控制菌检查:30~35℃培养箱中培养18~24小时
倾注计数用的的培养基平板置30~35℃培养箱中培养3天
倾注计数用的培养基平板置20~25℃培养箱中培养3~5天
特点:
(1)胰蛋白胨S培养基 它是1962年由Murashige和Skoog为培养烟草细胞而设计的。特点是无机盐和离子浓度较高,为较稳定的平衡溶液。其养分的数量和比例较合适,可满足植物的营养和生理需要。它的硝酸盐含量较其他培养基为高,广泛地用于植物的器官、花药、细胞和原生质体培养,效果良好。有些培养基是由它演变而来的。
(2)B5培养基 是1968年由Gamborg等为培养大豆根细胞而设计的。其主要特点是含有较低的铵,这可能对不少培养物的生长有抑制作用。从实践得知有些植物在B5培养基上生长更适宜,如双子叶植物特别是木本植物。
(3)White培养基 是1943年由White为培养番茄根尖而设计的。1963年又作了改良,称作White改良培养基,提高了MgSO4的浓度和增加了鹏素。其特点是无机盐数量较低,适于生根培养。
(4)N6培养基 是1974年朱至清等为水稻等禾谷类作物花药培养而设计的。其特点是成分较简单,KNO3和(NH4)2SO4含量高。在国内已广泛应用于小麦、水稻及其他植物的花药培养和其他组织培养。
(5)KM-80培养基 它是1974年为原生质体培养而设计的。其特点是有机成分较复杂,它包括了所有的单糖和维生素,广泛用于原生质融合的培养。
含量测定≥98%cytochrome c-1,CYC1 ELISA kit
英文名称:GLP-1 (7-36)锌指蛋白211抗体
英文名称:GLUT3锌指蛋白749抗体
英文名称:Gelsolin酸化zeta相关蛋白70抗体
英文名称:GHRHZ DNA结合蛋白抗体
英文名称:GFAP锌结合醇脱酶结构域蛋白1抗体
英文名称:GFP锌指蛋白481抗体
英文名称:GHR锌指蛋白ZBTB34抗体4-羟基酸(标准品)GoatF(ab)Anti-MouseIgGH&L(TexasRed®)
4-羟基苄醇;对羟基醇(标准品)RabbitAnti-MouseIgGH&L(FITC)
4-羟基间二酸(标准品)RabbitAnti-MouseIgGH&L(TRITC)
4-异基酸(标准品)RabbitAnti-MouseIgGH&L(TexasRed®)
4-[2-(5-氯-2-基酰)-基]-磺...RabbitAnti-MouseIgGH&L(Biotin)
4-差向四环素(标准品)RabbitAnti-MouseIgGH&L(HRP)
5'-脱-5-氟胞苷(5’-DFCR)(标准品)RabbitAnti-MouseIgGH&L(AlkalinePhosphatase)
5-水杨酸,美沙拉秦(标准品)RabbitAnti-RatIgGH&L(FITC)
5-基-2,4-二烯酸(标准品)RabbitAnti-RatIgGH&L(TRITC)
5-氮胞苷/阿扎胞苷(标准品)RabbitAnti-RatIgGH&L(TexasRed®)
5-基蜂蜜曲霉素(标准品)RabbitAnti-RatIgGH&L(Biotin)
5-羟基色氨酸(标准品)RabbitAnti-RatIgGH&L(HRP)
5-三氟基尿嘧啶(标准品)RabbitAnti-RatIgGH&L(AlkalinePhosphatase)
5-硝基糠二酸酯(标准品)RabbitAnti-GoatIgGH&L(FITC)
6-基-2-萘酮(标准品)RabbitAnti-GoatIgGH&L(TRITC)
胰蛋白胨朝藿定C进口/国产phospho-SYT6(Thr418) 酸化突触蛋白6抗体含量:Epmedin C
洛伐他汀进口/国产MtTF1 线粒体转录因子1抗体含量:Lovastatin
芒柄花黄进口/国产BarX1 BarX1蛋白抗体含量:Formononetin
拟人参皂苷F11进口/国产GOLPH2/GP73 高尔体膜蛋白GP73抗体含量:Pseudoginsenoside F11
人参皂苷Rb1进口/国产phospho-CstF64(Ser83) 酸化细胞分裂相关蛋白CSTF64抗体含量:Ginsenoside Rb1
人参皂苷Rb2进口/国产TET1/CXXC6 Ten-eleven转运因1蛋白抗体含量:Ginsenoside Rb2
人参皂苷Rb3进口/国产Calcium Sensing Receptor/CaSR 钙敏感受体1抗体含量:Ginsenoside Rb398%20mgPeroxiredoxin 4,PRDX4 ELISA Kit
英文名称:phospho-Eg5(Thr926)分选连接蛋白11抗体
英文名称:EID1分选连接蛋白6抗体
英文名称:EB3子生成相关蛋白3抗体
英文名称:EIF5酸化非受体酪氨酸激酶c-Abl抗体
英文名称:ELAC2SRC有丝分裂相关蛋白68抗体
英文名称:phospho-MEK1 (Ser385)SH3BGRL2蛋白抗体
英文名称:phospho-MEK1 (Thr292)钠离子通道相关蛋白1抗体
风险提示:丁香通仅作为第三方平台,为商家信息发布提供平台空间。用户咨询产品时请注意保护个人信息及财产安全,合理判断,谨慎选购商品,商家和用户对交易行为负责。对于医疗器械类产品,请先查证核实企业经营资质和医疗器械产品注册证情况。
技术资料暂无技术资料 索取技术资料
胰蛋白胨厂家
询价